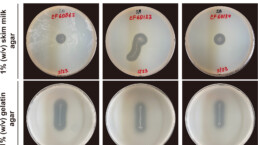

Welcome to Leehicam Lab.
We strive for providing bio-based solutions to safer, healthier and smarter ingredients and processes
Lab. of Food and Biosystems Engineering
Dept. of BiotechnologyCollege of Life Science and BiotechnologyYonsei University
Our lab strives to understand the structure-function relationship of primordial enzymes, and to define the factors governing the thermostability and substrate specificity of extremozymes engaged in sugar isomerization, protein degradation, and redox catalysis. We are also involved in exploring the anaerobic metabolism of extremophiles under harsh environments, and to define the thresholds of minimal cellular function and molecular adaptation. Toward this aim, we employed a variety of advanced multi-omics technologies including the next-generation sequencing, directed evolution, and MS2 spectrometry to understand how extremophiles have been evolved under harsh environments. In parallel to these investigations, we are exploring the possibility of creating much promiscuous and thermostable versions of the highly specific, thermo-labile counterparts to reveal the minimal requirements for function. The goal is to design and engineer protein that will provide a variety of repertoires of non-natural enzyme activity, potentiating the design and development of novel biological processes for industrial applications.